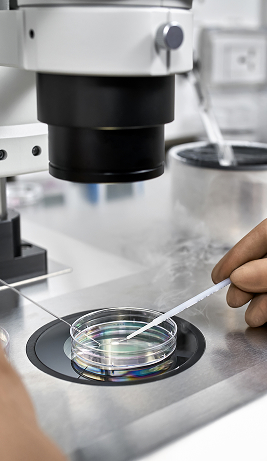

Fertility Doctor in Los Angeles, CA
Genuine Care
Proven Success

- High success rates that exceed national averages
- Certified state-of-the-art laboratory in Encino
- Four convenient locations across Los Angeles
- Flexible financing options to support your journey
A World-Class Laboratory
Our IVF lab in Encino is fully certified by the College of American Pathologists and equipped with RI Witness™, a radio frequency ID system that safeguards every step of the IVF process. With over 30 years of experience in assisted reproductive technology, our team delivers precision-driven care that patients can trust with success rates that reflect it.
Over 30 years of experience
Exceptional IVF Success Rates

Our IVF success rates consistently exceed national averages, and the results speak for themselves. Among patients ages 38 to 40, our success rate for live births is 69%, compared to the national average of just 40%, according to the most recent data. Families come from around the world for this level of care, trust, and proven outcomes.
Our Live Birth success rate is 69%
Linda and Richard’s Fertility Success Story
When Linda and Richard visited our office and met with Dr. Vermesh, they immediately felt informed, comfortable, and hopeful. “He really is a great doctor,” says Linda. “He is very caring.” Richard agrees, saying, “It's like a very strong support team that you have around you. So I would recommend him to anybody, literally to anybody.”
"We are repeat customers."

Where Every Journey Matters
At our Los Angeles fertility clinic, every patient receives expert, individualized care from a trusted team of doctors. Drs. Michael Vermesh and Tannaz Toloubeydokhti combine advanced reproductive technology with a truly supportive experience, welcoming patients from around the world with staff fluent in English, Farsi, and Japanese. Here, your care is as personal as your path to parenthood.
“Truly Top Notch!!”
“Dr Vermesh is so kind and has the best bedside manner. Also, all of the nurses are SO sweet and patient and caring. I feel like they have all been such an encouraging part of this process and I love seeing their smiling faces each time I go in. I scream Dr Vermesh’s name from the rooftops because he is truly top notch!!” – Kati, 5-Star Review
Expert Fertility Care
The Center for Fertility and Gynecology was established in 1987 by Dr. Michael Vermesh to help Los Angeles, CA, patients grow their families. We offer a range of comprehensive fertility treatments using the latest in reproductive techniques and technology to help you fulfill your dreams of parenthood.
Our fertility specialists offer couples the best possible evaluation, diagnosis, and treatment of both female and male infertility in a patient-oriented, supportive setting. We proudly provide LGBTQ family planning in Los Angeles, CA, and welcome non-traditional families. Our team is honored to help members of the LGBTQ+ community expand their families with inclusive, compassionate care.

We Serve Los Angeles and Beyond
Hear From Our Specialists
Dr. Michael Vermesh and Dr. Tannaz Toloubeydokhti discuss our individualized approach to fertility care at the Center for Fertility and Gynecology, a leading Tarzana-based practice recognized for exceptional pregnancy success rates.
“We’re very proud of our customized care.”
Comprehensive Services
“Truly exceptional.”
“Dr. Tolu (and her staff) are truly exceptional. After just one month under her care, my partner and I were thrilled to find out we were expecting. From the very first appointment, she was thorough, compassionate, and genuinely invested in our journey... We are so grateful to have found her and can’t recommend her enough!” — Lilit, 5-Star Review